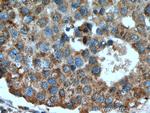
RABIF Antibody in Immunohistochemistry (Paraffin) (IHC (P))

Search
Proteintech
RABIF Polyclonal Antibody
{{$productOrderCtrl.translations['antibody.pdp.commerceCard.promotion.promotions']}}
{{$productOrderCtrl.translations['antibody.pdp.commerceCard.promotion.viewpromo']}}
{{$productOrderCtrl.translations['antibody.pdp.commerceCard.promotion.promocode']}}: {{promo.promoCode}} {{promo.promoTitle}} {{promo.promoDescription}}. {{$productOrderCtrl.translations['antibody.pdp.commerceCard.promotion.learnmore']}}
产品信息
29113-1-AP
种属反应
宿主/亚型
分类
类型
抗原
偶联物
形式
浓度
规格
纯化类型
保存液
内含物
保存条件
运输条件
产品详细信息
Immunogen sequence: MEPAEQPSEL VSAEGRNRKA VLCQRCGSRV LQPGTALFSR RQLFLPSMRK KPALSDGSNP DGDLLQEHWL VE
靶标信息
The Sec4/Rab-related small GTP-binding proteins are involved in the regulation of intracellular vesicular transport. Mss4 stimulates GTP-GDP exchange in Sec4 and Rab and binds to a subset of genetically related Rab proteins.
仅用于科研。不用于诊断过程。未经明确授权不得转售。
篇参考文献 (0)
生物信息学
蛋白别名: Guanine nucleotide exchange factor MSS4; mammalian suppressor of SEC4; Rab-interacting factor; Ras-specific guanine-releasing factor 3; unnamed protein product; Zn2+ binding protein/guanine nucleotide exchange factor
基因别名: AI842864; AW549708; E130318E12Rik; MSS4; RABIF; RASGFR3; RASGRF3
UniProt ID: (Human) P47224, (Mouse) Q91X96
Entrez Gene ID: (Human) 5877, (Mouse) 98710